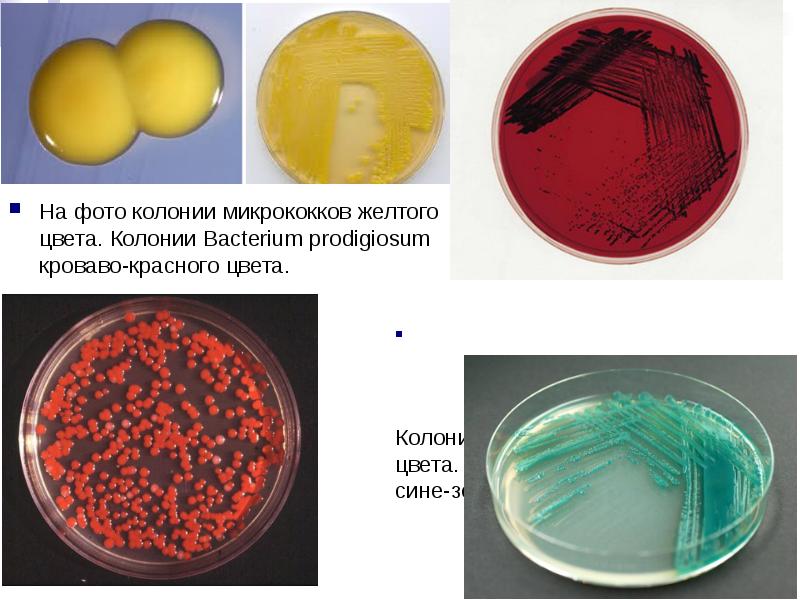
На фото колонии микрококков желтого цвета. Колонии Bacterium prodigiosum кроваво-красного цвета.

Заповедники Красноярского края В Красноярском крае создано семь презентация
Содержание
- 10. Прокариотическая клетка
- 12. Клеточная теория
- 14. У современных и ископаемых организмов известны два типа клеток: прокариотическая и
- 16. Эукариоты Эукариотические клетки больше по размеру и имеют более сложную
- 20. Прокариоты Средняя величина прокариотических клеток 5 мкм. 1 мкм
- 25. Бактерии – «великие могильщики природы» Луи Пастер. Эти маленькие организмы создали
- 26. Происхождение прокариот Первоначально появились в анаэробной среде 2,5-3 млрд. лет назад
- 27. Среда обитания прокариот Атмосфера Гидросфера Литосфера Внутри клеток (облигатные симбионты), паразиты
- 28. Размеры Размеры бактериальных клеток колеблются в пределах от 1 до 10-15
- 29. Форма Кокки Диплококки Тетракокки
- 30. Форма Стрептококки
- 31. Форма Сарцины Стафилококи Палочки (бациллы)
- 32. Форма Спириллы Спирохеты Вибрионы
- 35. Строение бактериальной клетки 1 — клеточная стенка, 2 — наружная цитоплазматическая
- 36. Волютин ВОЛЮТИН, цитоплазматические включения в виде гранул полифосфата у микроорганизмов. Впервые
- 37. Мезосома Мезосомы — складки цитоплазматической мембраны бактерий, образующиеся при использовании химических методов фиксации во время подготовки
- 38. Строение бактериальной клетки На поверхности бактерий часто заметны разного рода жгутики
- 39. Пили (ворсинки) Пили, фимбрии или ворсинки — поверхностные структуры, присутствующие у многих бактериальных клеток и представляющие собой прямые белковые
- 40. Строение бактериальной клетки Клеточная стенка прокариот жесткая, содержит полисахариды и аминокислоты.
- 41. Строение бактериальной клетки Основная особенность – отсутствие ядра, ограниченного оболочкой. Наследственная
- 42. Константа седиментации (скорость оседания в ультрацентрифуге) у цитоплазматических рибосом эукариотических клеток
- 43. Центрифу́га — устройство (машина или прибор), служащее для разделения сыпучих тел
- 44. в сельском хозяйстве для очистки зерна, выдавливания мёда из сот, выделения
- 45. Нуклеоид Нуклеоид является аналогом ядра. Он расположен в центре клетки.
- 46. Плазмиды Плазмиды представляют собой автономные молекулы свернутые в кольцо ДНК. Их
- 47. Обмен веществ По отношению к кислороду прокариоты делятся на две группы:
- 48. На фото газовая гангрена. Заболевание вызывается анаэробными бактериями рода клостридиум.
- 49. Аэробные бактерии (аэробы) Облигатные аэробы развиваются только при наличии достаточного
- 50. На фото аммонифицирующие бактерии подвергают останки погибших животных и растений разложению.
- 51. Питание По способам питания делятся на: автотрофы - получают энергию за
- 52. Автотрофы живут в кислородной среде и с целью получения углерода и
- 53. Гетеротрофные бактерии Гетеротрофные бактерии используют для построения своего организма и
- 54. Ферменты бактерий Ферменты бактерий Витамины входят в
- 55. Питательные вещества и ионы проникают в бактериальную клетку тремя путями: Пассивная
- 56. Размножение У бактерий выделяют два способа размножения: путем деления клетки надвое
- 57. Как только репликация ДНК завершилась, в результате синтеза клеточной стенки появляется
- 58. У сенной палочки процесс репликации ДНК завершается обменом участками 2-х ДНК.
- 59. Типы делений бактериальных клеток Если клеточное деление опережает процесс разделения,
- 60. Коньюгация В 1946 году учеными было обнаружено половое размножение в примитивной
- 61. Спорообразование Многим бактериям свойственно спорообразование. Споры возникают, когда ощущается недостаток в
- 62. Пигменты бактерий Почти все бактерии в процессе своей жизнедеятельности вырабатывают
- 63. На фото колонии микрококков желтого цвета. Колонии Bacterium prodigiosum кроваво-красного цвета.
- 64. Светящиеся и ароматообразующие микроорганизмы
- 65. Роль в природе Роль бактерий в природе носит глобальный характер.
- 66. На фото корни бобовых растений. Усваивать самостоятельно азот из воздуха бобовые
- 67. Бактерии-паразиты Паразиты – это бактерии, которые питаются за счет клеток живых
- 68. Использование человеком Получение многих пищевых и технических продуктов невозможно без участия
- 71. Отрицательная роль бактерий Различные виды гнилостных бактерий вызывают порчу пищевых продуктов.
- 72. Определить родовое понятие, содержание, объем, основу деления животные, жизнь, высшие
- 73. Цианобактерии Цианобакте́рии (лат. Cyanobacteria, сине-зелёные во́доросли,цианопрокариоты или цианеи[1], от греч. κυανός — сине-зелёный) — значительная группа крупных грамотрицательных бактерий, способных к фотосинтезу, сопровождающемуся
- 74. Составьте вопрос-суждение Цианобактерии наиболее близки к древнейшим микроорганизмам, остатки которых
- 76. Строматолиты – тонкослойчатые колонны или холмики, состоящие из карбоната кальция (кальцита).
- 77. Строматолиты
- 78. Плотно сплетаясь и образую кремнистую корочку на поверхности, бактерии защищали себя
- 79. Цианобактерии являются объектом исследования как бактериологов (как прокариоты), так и альгологов (как организмы физиологически схожие с эукариотическими водорослями).
- 82. Морские и пресноводные, почвенные виды, участники симбиозов (например, в лишайнике). Составляют значительную долю океанического фитопланктона.
- 87. Первые диазотрофные бактерии были выделены С. Н. Виноградским в 1898
- 88. Механизм повышенного уровня дыхания. Azotobacter chroococcum при азотфиксации окисляет часть органического вещества, не
- 89. Легоглоби́н Легоглоби́н — разновидность гемоглобина, содержащаяся в клубеньках бобовых растений и придающая им красный цвет.
- 90. Цианобактерии, по общепринятой версии, явились «творцами» современной кислородсодержащей атмосферы на Земле,
- 91. Гуро́нское оледене́ние — одно из древнейших и наиболее продолжительных оледенений на Земле.
- 92. Брожение известно людям с незапамятных времен. Тысячелетиями человек пользовался спиртовым брожением
- 93. Спиртовое брожение — это процесс окисления сахаров, в результате которого образуются этиловый
- 94. Гомоферментативное молочнокислое брожение вызывают бактерии рода Lactobacillus и стрептококки. Они могут
- 95. Молочная кислота находит широкое применение в производстве кож, красильном деле, при
- 96. Наряду с масляной кислотой, углекислым газом и водородом образуются этиловый
- 97. Скачать презентацию

![Цианобактерии
Цианобакте́рии (лат. Cyanobacteria, сине-зелёные во́доросли,цианопрокариоты или цианеи[1], от греч. κυανός — сине-зелёный) — значительная группа крупных грамотрицательных бактерий, способных к фотосинтезу, сопровождающемуся Цианобактерии
Цианобакте́рии (лат. Cyanobacteria, сине-зелёные во́доросли,цианопрокариоты или цианеи[1], от греч. κυανός — сине-зелёный) — значительная группа крупных грамотрицательных бактерий, способных к фотосинтезу, сопровождающемуся](/documents_7/5250bcb3174129eca8d53e7a05ad5243/img72.jpg)























Слайды и текст этой презентации
Скачать презентацию на тему Заповедники Красноярского края
В Красноярском крае создано семь можно ниже:
Похожие презентации





























